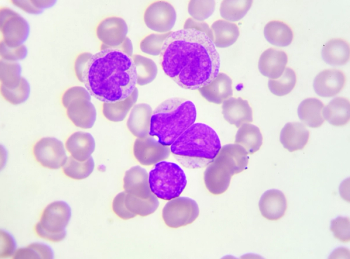

Health care practitioners and manufacturers must change practice patterns and management strategies.

Health care practitioners and manufacturers must change practice patterns and management strategies.

Individuals with an average risk of colorectal cancer said they would prefer a stool-based screening test for colorectal cancer over colonoscopy.

The relatively new combination of PD-1/PD-L1 inhibitors with VEGF inhibitors represents a promising option for patients with various malignancies.

Prevention methods, including smoking cessation and public education, remain critical in combating the United States’ third most common cancer type.

Pharmacists must work to keep patients informed and safe so they can continue to deliver lifesaving cancer care.

Directions in Oncology Pharmacy® is getting to know oncology pharmacy professionals through a series of interviews. In this issue, we talk to David DeRemer, PharmD, BCOP, FCCP, FHOPA, president of the Hematology/Oncology Pharmacy Association (HOPA) Board of Directors, whose term ends this month.

As the most accessible member of the health care team, the pharmacist can provide patients with cancer with the information and support necessary to get through what could be the most challenging time in their lives.

Clinicians should consider the impact on subsequent therapies, overall survival, and median time to definitive deterioration with CDK 4/6 inhibitors.

Cynthia Lynch, MD, breast cancer program clinical advisor with Cancer Treatment Centers of America, said oncology pharmacists are vital team members who can help ensure optimal treatment and safety for patients with breast cancer.

Investigators developed a genetically distinct and non-toxic strain of salmonella called CRC2631 to select and kill cancer cells, which may be able to be tailored to specific patients.

Oncology experts recommend patients schedule overdue screenings, as pandemic restrictions ease.

Loncastuximab tesirine-lpyl is a CD19-targeted antibody drug conjugate.

According to the study authors, the findings suggest a need for greater transparency in health care pricing as well as policies eliminating financial obstacles to catching cancer early.

Novel therapeutics under investigation include CAR T-cell therapies, antibody-drug conjugates, and bispecific antibodies, as well as other unique drugs.

New research findings published in Cell Reports identified a type of immune cells that acts as a major driver of breast cancer growth by preventing the accumulation of a specific protein that induces anti-tumor responses.

The study further explored the various aspects of financial hardships, including material, psychological, and behavioral measures.

Immunotherapies will continue to change standards of care for treatment of RCC.

One mutated version of KRAS that commonly arises in cancer cells is called KRAS(G12C) and it produces a mutated KRAS protein that allows the cells to grow and spread in the body.

The study shows that brentuximab vedotin allowed for reduced radiation exposures and resulted in fewer adverse effects for patients, according to its authors.

A new study led by researchers at NYU Rory Meyers College of Nursing found that breast cancer survivors with a higher risk of cancer recurrence based on genomic testing may experience greater fear of their cancer returning.

A new study shows that overweight breast cancer survivors have a statistically significant increased risk of developing second primary cancers, and obesity is strongly associated with an increased risk of various cancer types.

Nivolumab is the first and only immunotherapy in combination with chemotherapy to deliver superior overall survival compared to chemotherapy alone in this patient population.

Among somatic mutations, approximately 89% of patients with metastatic castration-resistant prostate cancer have a potentially actionable mutation.

Hematology/Oncology Pharmacy Association plans to develop tools and resources to support those conducting research in the oncology pharmacy field, with the goal of promoting pharmacist-led research and improving the ability to analyze difficult scientific questions.

Patient interactions became vastly different during the pandemic, with questions surrounding how to coordinate contact and how to best provide pharmacy services virtually, including counseling, fielding drug information questions, medication reconciliation, and providing home medication sheets to families

Olaparib and niraparib both show promise in the maintenance treatment of ovarian cancer, though they may each be appropriate for different patient populations.

Pharmacokinetic differences in pediatric patients should be considered when administering direct oral anticoagulants, as should potential administration difficulties when pellets or oral solutions are not available.
Selection of any BTK inhibitors for mantle cell lymphoma should consider factors such as cardiovascular or bleeding risks, predisposition for gastrointestinal adverse effects, and potential medication nonadherence.

CLL is the most common leukemia in adult patients in the western world, with 21,040 estimated new cases in 2020.

For unresectable gastrointestinal stromal tumors, the introduction of imatinib revolutionized treatment.